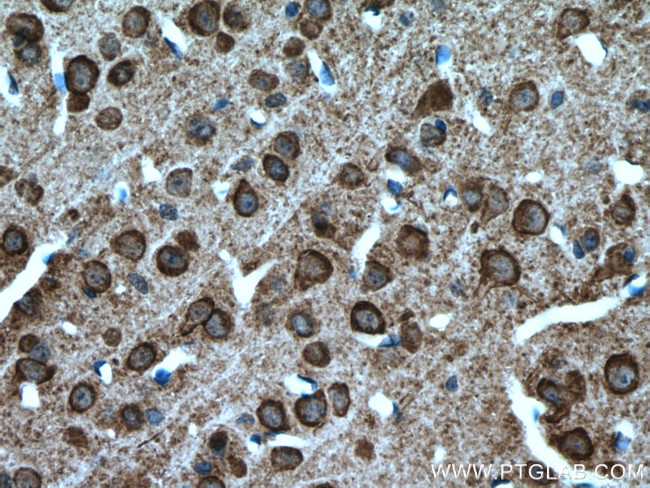
SLC4A10 Antibody in Immunohistochemistry (Paraffin) (IHC (P))

Search
Proteintech
SLC4A10 Polyclonal Antibody
{{$productOrderCtrl.translations['antibody.pdp.commerceCard.promotion.promotions']}}
{{$productOrderCtrl.translations['antibody.pdp.commerceCard.promotion.viewpromo']}}
{{$productOrderCtrl.translations['antibody.pdp.commerceCard.promotion.promocode']}}: {{promo.promoCode}} {{promo.promoTitle}} {{promo.promoDescription}}. {{$productOrderCtrl.translations['antibody.pdp.commerceCard.promotion.learnmore']}}



Please note: We are reviewing Western blot images included in the antibody testing data in our catalog, including those provided by third parties. Unless expressly labeled or annotated as “raw-unedited”, Western blot images included in the antibody testing data in our catalog may have been edited, optimized or otherwise adjusted for presentation.
产品信息
27197-1-AP
种属反应
宿主/亚型
分类
类型
抗原
偶联物
形式
浓度
规格
纯化类型
保存液
内含物
保存条件
运输条件
产品详细信息
Immunogen sequence: TRNDEEAVVD RGGTRSILKT HFEKEDLEGH RTLFIGVHVP LGGRKSHRRH RHRGHKHRKR DRERDSGLED GRESPSFDT
靶标信息
Members of the SLC4 bicarbonate transporter family are involved in solute transport and pH homeostasis. NCBE (SLC4A10) is a member of the SLC4 family of bicarbonate transporters, several of which play important roles in intracellular-pH regulation and transepithelial HCO(3)(-) transport. The SLC4A10 gene, which is highly expressed in the mammalian brain, contains two known alternative splicing units, inserts A and B. SLC4A10 encodes a sodium bicarbonate transporter with a brain-restricted expression pattern. Slc4a10 knockout (KO) mice have collapsed brain ventricles and display an increased seizure threshold, while heterozygous deletions in man have been associated with idiopathic epilepsy and other neurological symptoms. Slc4a10 is a promising pharmacological target for the therapy of epilepsy or elevated intracranial pressure.
仅用于科研。不用于诊断过程。未经明确授权不得转售。
篇参考文献 (0)
生物信息学
蛋白别名: NBCN2; NCBE; sodium bicarbonate cotransporter member 10 variant NBCn2-E'; sodium bicarbonate cotransporter NBCn2-E; Sodium-Driven Chloride Bicarbonate Exchanger; Solute carrier family 4 member 10
基因别名: Kiaa4136; mKIAA4136; NBCN2; NCBE; SLC4A10
UniProt ID: (Mouse) Q5DTL9
Entrez Gene ID: (Mouse) 94229